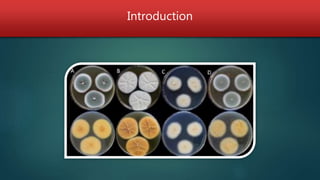
Introduction

Epigenetics, including DNA methylation, chromatin remodeling, and RNA interference, can be used as tools to improve fungal strains for biotechnology. Three main levels of epigenetic regulation are DNA methylation, histone modification through chromatin remodeling, and RNA interference. Research has shown that targeting chromatin modification through histone methyltransferases, deacetylases, and other enzymes that regulate gene expression promises to be an effective approach for strain improvement, though DNA methylation appears to play a more limited role in fungi. Future work is likely to focus on exploiting these epigenetic mechanisms, particularly histone modifiers, to optimize fungal strains for industrial applications.

![COMPASS and regulation of secondary metabolites in fungi
COMPASS (complex proteins associated with Set1) ]
In Saccharomyces cerevesiae….. is involved in H3K4 mono-, di-, and tri-methylation which is
necessary for RNA Pol II binding and transcriptional activity in development and differentiation
In A. nidulans …….. CclA (Bre2 in S. cerevisiae) is one of the eight members of COMPASS
The lack of CclA leads to reduced levels of H3K4 and H3K9 di- and tri-methylation, as well as reduced
H3 acetylation
in S. cerevesiae ….. H3K4 di- and tri-methylation is associated with actively expressed genes and
are required for telomere silencing
A. nidulans ………… H3K4 di- and tri-methylation is associated with actively expressed genes and are
required for activating SMs e.g. monodictyphenone, emodins, and the polyketides F9775A and
F9775B
In A. fumigatus……….loss of CclA results in slow fungal growth and increased SM production like
gliotoxin](https://image.slidesharecdn.com/epigenetics-170822193923/85/Epigenetics-modification-in-fungi-27-320.jpg)





